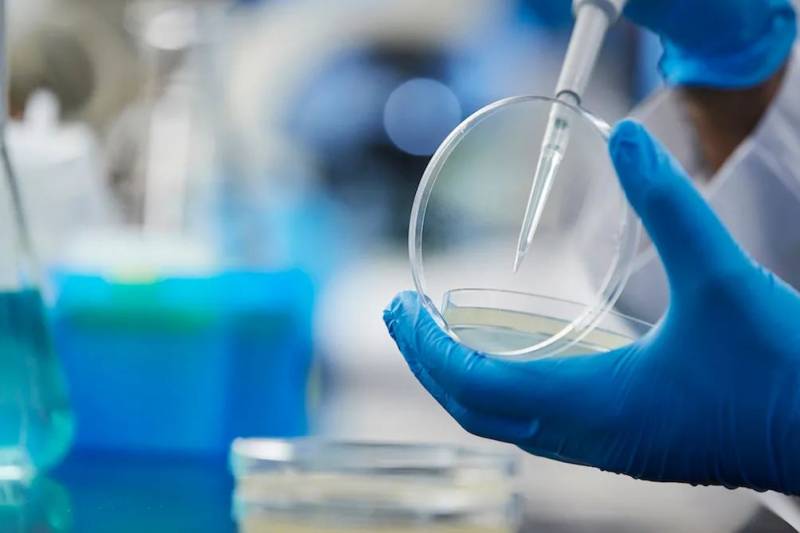
再也不用戳鼻孔！新加坡发明的超舒适新冠检测方法来啦

再也不用戳鼻孔!新加坡发明的超舒适新冠检测方法来啦
新冠检测中的鼻咽拭子检测,可以说是令人闻之色变了。这个检测要深入地“插鼻孔”,舒适度可以说是相当不咋地了~

图源:theconversation
不过最近,在新加坡,有个名字为“RESOLUTE 2.0”的新冠检测盒通过批准,即将与大家见面啦!!
这个检测盒可以免除鼻孔被蹂躏的痛苦哟!!这可极大解救了需要频繁做新冠检测的那些朋友了啊!!

图源:海峡时报
“RESOLUTE 2.0”检测盒是用深喉唾液检测冠病病毒的定量反转录聚合酶链式反应(请大家不要联系到污污污那些事儿,我们是个很正经的公众号哦~)。
只需要大家把嗓子眼深处的唾液吐进检测盒里,就可以检测新冠病毒啦~ 也不用插鼻孔,也不用抽血,只用“啊咳呸”吐个口水就可以检测新冠!!这舒适度可以说是爆表了!!
而且别的新冠检测方式还都需要医护人员来采集样本,“RESOLUTE 2.0”检测盒可以由测试者自行完成,省多大事儿啊!!
深喉唾液检测由国防科技研究院(DSO National Laboratories)和新加坡科技研究局(A*STAR)联手研发。

图源:A*STAR
该检测盒的临床表现得到了新加坡科技研究局属下的医疗诊断发展中心、淡马锡基金会、医疗保健公司Sheares Healthcare、樟宜综合医院、国防科技研究院以及兀兰医疗园的临床研究的支持。
这个检测盒检测过程简单,效率极高,特别适合在流动人口多的地方使用。

图源:biospectrumasia
这不,计划明年开放的樟宜机场的检测冠病样本的专用实验室,就要用上这个RESOLUTE 2.0检测盒了。
据说到时候,樟宜机场实验室的检测样本数能达到现在使用的常规RT-PCR检测实验室的四倍以上呢~这也特别有利于边境的进一步开放啊~

图源:海峡时报
其实,深喉唾液检测盒已经在中国香港广泛使用了。
香港政府还曾在普通科门诊派发新冠样本收集包给自己觉得自己有新冠感染风险的市民使用。
这个小小的新冠样本收集包有深喉唾液样本采集指引和样本收集瓶及样本瓶包装袋,市民们可以自行采样,然后填好化验所需的资料,再在规定时间内把样本收集包交到指定地点。

图源:香港政府官网
如此一来,几十间诊所联动协作,收集样本,这样就可以非常快捷地及早找到新冠患者,及时阻断新冠病毒的进一步传播。
现在,新加坡有很多种新冠检测方式:准确度超高的PCR检测、鼻咽拭子检测、半个小时内可以出结果的抗原快速检测等。

图源:卫报
这次,再加上这款可以准确识别临床研究中所有的阳性病例的RESOLUTE 2.0检测盒,新加坡的新冠防线可以说是牢不可破啦~~
而且说句真心话,如果这款新冠检测盒普及开来,在价格不太高的情况下,估计很多人都愿意自费负担检测盒的。
图源:biospectrumasia
毕竟在这个新冠疫情的特殊时期,得个感冒都吓得要死,这样能及时用检测盒自测的话,小感冒也可以不用去医院了,还能把医疗资源节省下来留给最需要的人,岂不美哉~
亲爱的椰友们,你们期待这款深喉唾液新冠检测盒的普及吗?
评论